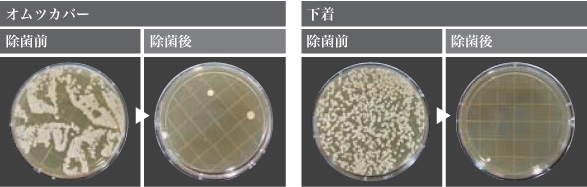

目には見えなくても、私たちが暮らす日常空間には様々な細菌が潜んでいます。その対策として有効な手段が、塩と水で電気分解して生成する「電解水」。洗浄力の「アルカリ性電解水」と除菌力の「酸性電解水」が、施設の衛生管理に活躍します。しかも生成には薬品類を一切使用しないため、安心してご使用いただけます。
食品業界や福祉施設をはじめ幅広いシーンで、清潔な環境作りをサポートします。
環境衛生事業
電解水衛生環境システム 守る水


洗浄用水だけでなく、洗濯にも使用可能。洗剤やボイラー代の削減に効果を発揮します。
洗浄&除菌。W効果の電解水。汚れの中に潜む菌も、効果的に除去します。
菌が汚れの中に潜んでいる場合、通常の除菌剤だけでは菌を覆っている汚れにガードされてしまい、充分な除菌効果を発揮することができません。そこで、洗浄力&除菌力、W効果の電解水です。「アルカリ性電解水」で細菌の温床や臭いの元となるたんぱく質・油汚れを分解洗浄。その後、「酸性電解水」で菌を除去します。

電解水の生成に必要なのは、「水」と「塩」と「電気」だけ。
「水」、「塩」、「電気」から生成される電解水。
私たちが普段の生活でよく使うものを原料として「除菌水」や「洗浄水」が作られます。
「安全・安心」な原料から生まれる、「安全・安心」な環境を「守る水」。
この水を作り出す「マルチセル型電解槽」には、多くのノウハウと可能性がつまっています。
マイナス(-)の電極側から洗浄力の高いpH約12.0のアルカリ性電解水と、プラス(+)の電極側から除菌力の高いpH約3.0(有効塩素濃度20~70mg/kg)の酸性電解水が生成されます。

電解水はさまざまな場所で実用されています
スーパーの食品売り場フロアから陳列棚まで。電解水をスプレー容器で使用すれば隅々まで除菌できます。
老人福祉施設の洗濯水洗浄と除菌、電解水のW効果は洗濯に最適。肌にもやさしいので敏感肌の方も安心です。
ホテルの客室噴霧器を利用して客室全体を効果的に除菌。脱臭効果でお部屋の臭いもすっきり。
食品工場の衛生管理清潔な調理環境のために。しつこい汚れの分解や確実な除菌には漬け置きも効果的です。
温浴施設の掃除床に、浴槽に、椅子に、タイルの目地に発生しやすいカビの原因菌を除菌します。
ビルメンテナンス人の通行が多いロビー、通路に。二度拭きが要らないため、清掃も効率よく短時間で。
型式 | ESS-ZERO |
---|---|
電源 | 単相100V 50Hz/60Hz 1.0kVA(10A) |
消費電力 | 定格消費電力:650W 平均消費電力:143W |
外形寸法 | 幅500mm×奥行500mm×高さ820mm |
電解水pH | 酸性電解水:3.0 アルカリ性電解水:約12.0 |
有効塩素濃度 | 20~70mg/kg(現地水質及び用途により調整) |
生成量 | 酸性電解水:最大約5.0L/min アルカリ性電解水:最大5.0L/min(調整可) |
製品重量 | 乾燥重量/約72kg |
給水/排水 | 給水:上下水道(給水圧0.2~1.0MPa) 排水:背圧がかからないこと |
日量使用目安 | 酸性電解水・アルカリ性電解水 合計2t/日(現地水質及び用途により調整) |
使用温度範囲 | 5℃~35℃ |
設置場所 | 屋内(床置式、要排気設備、凍結・結露しない場所であること) |
※農業用には塩化カリウムを使用します。
除菌電解水給水機

■酸性電解水とは
微量の精製塩や希塩酸と水を電気分解して生成される水。酸性電解水に含まれる次亜塩素酸が高い除菌効果を発揮します。その安全性から洗浄・除菌への使用が可能です。
「原液の希釈」といった手間が要らない。そのまますぐに使えるから、とても使いやすい。

- ■手をかざすだけで出てくる非接触式ハンドセンサー
- ■用途に合わせて塩素濃度レベルが変えられる。
LEVEL1(10mg/kg)~LEVEL5(30mg/kg) - ■ハンドセンサーによる「吐出時間」が変えられる
[10~120秒 1秒単位で設定可能] - ■生成スイッチによる「生産量」が変えられる
[1~200L 1L単位で設定可能]
ご提案先は、“清潔を大切にする方たち”です
【主な導入先】幼稚園・老人福祉施設・オフィス・スポーツジム・食品工場などの手洗い場
電解水手洗いで、施設、工場などの職員の衛生管理にお役立てください。
型式 | AT-01S |
---|---|
電源 | AC100V 50/60Hz |
消費電力 | 定格消費電力:60W |
本体寸法 | 幅270mm×奥行110mm×高さ303mm |
電解水pH | pH5.0~6.5 ※調整可能です。また、水道水の水質や周辺環境等により変化致します。 |
有効塩素濃度 | 10~30mg/kg(現地水質により調整) |
生成量 | 約2.5L/min ※水道水の水質や周辺環境等により変化致します。 |
重量 | 乾燥重量/約3.6kg |
給水圧 | 0.1MPa~0.75MPa(推奨0.20MPa以上) ※0.75MPaを超える場合は必ず外部減圧弁を取り付けること |
設置場所 | 屋内 |
給水方式 | 元止め方式 |
超音波式噴霧器
超音波式噴霧器 プロミスト(PDFで開きます)